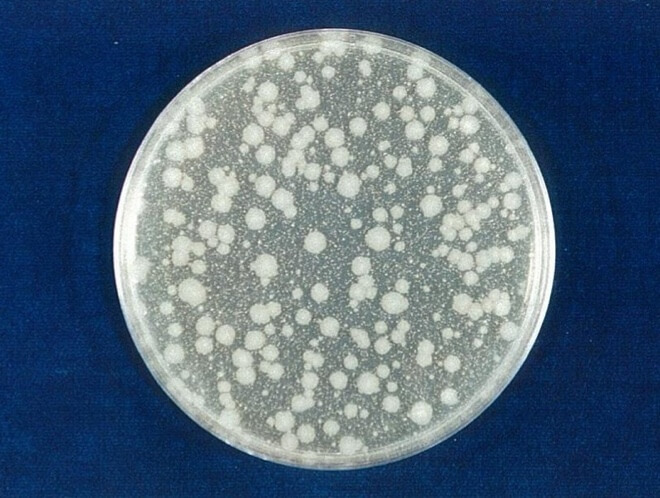
大腸菌 開始時（共通写真）
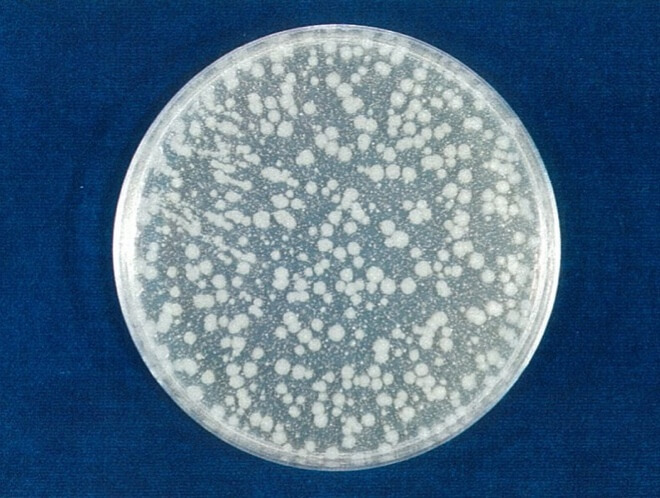
大腸菌 対照 4時間後（写真-3）
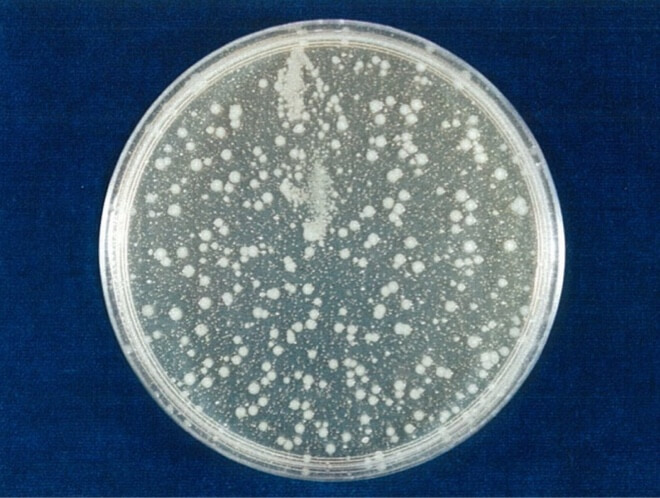
大腸菌（O157:H7） 開始時（共通写真）
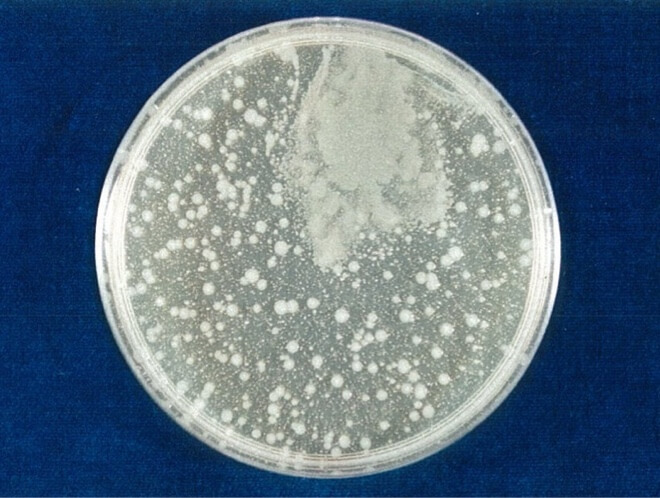
大腸菌（O157:H7） 対照 4時間後（写真-3）
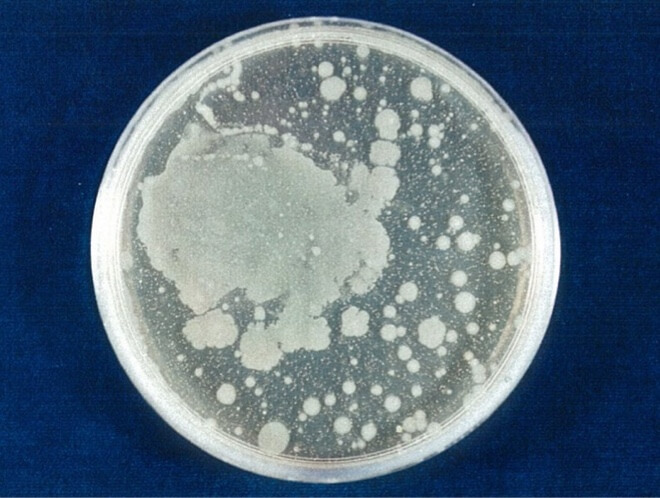
大腸菌（O157:H7） 対照 24時間後（写真-5）
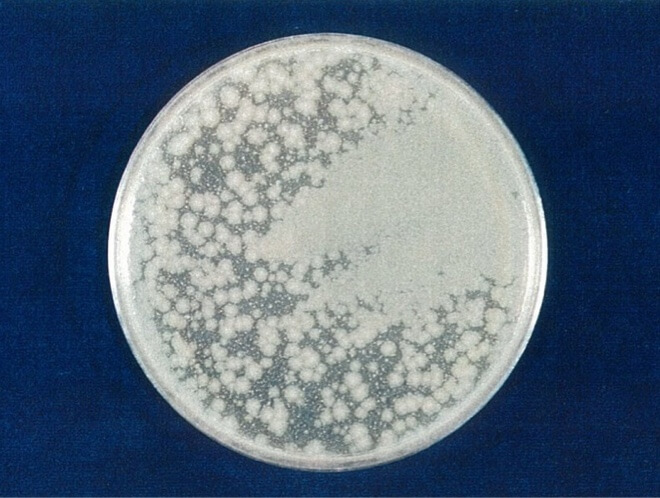
緑膿菌 対照 4時間後（写真-3）
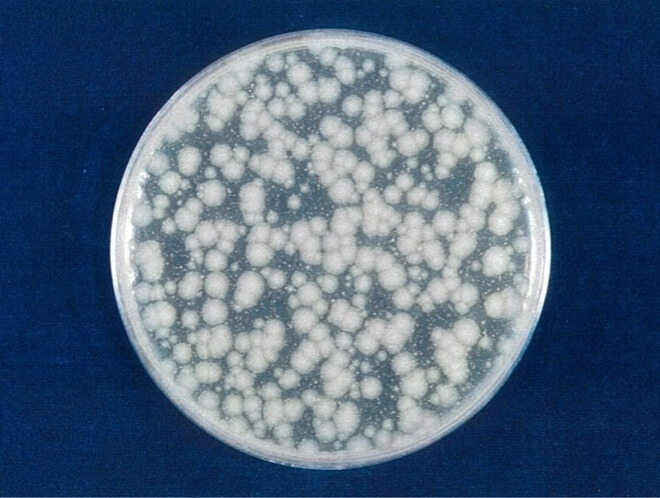
緑膿菌 対照 24時間後（写真-5）
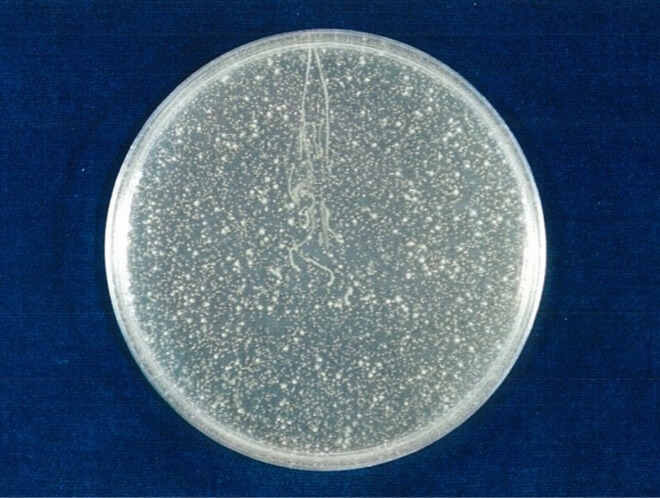
黄色ブドウ球菌 開始時（共通写真）
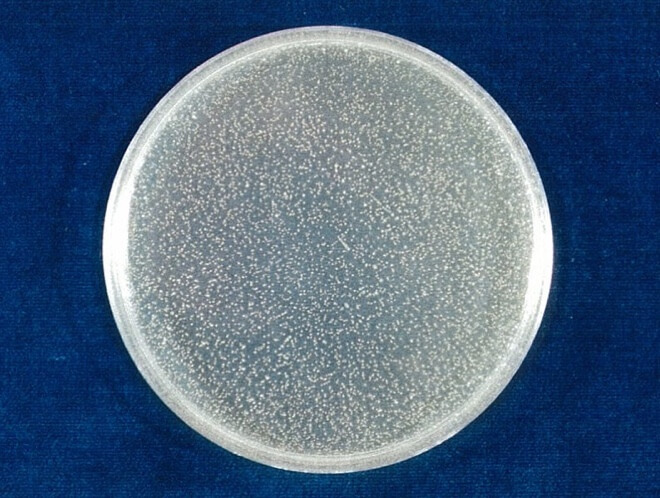
黄色ブドウ球菌 対照 4時間後（写真-3）
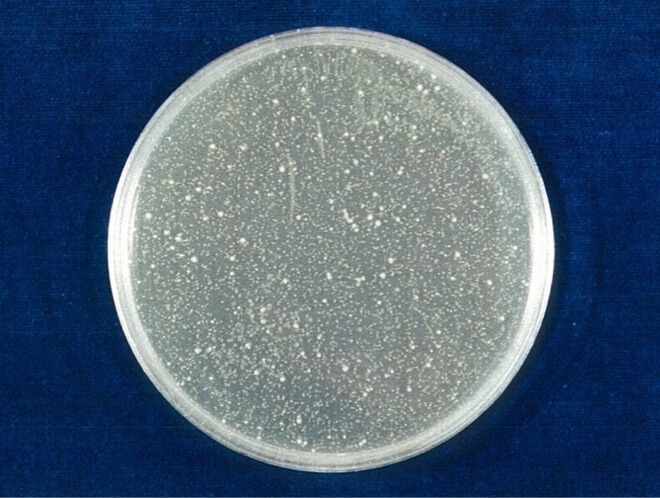
黄色ブドウ球菌 対照 24時間後（写真-5）
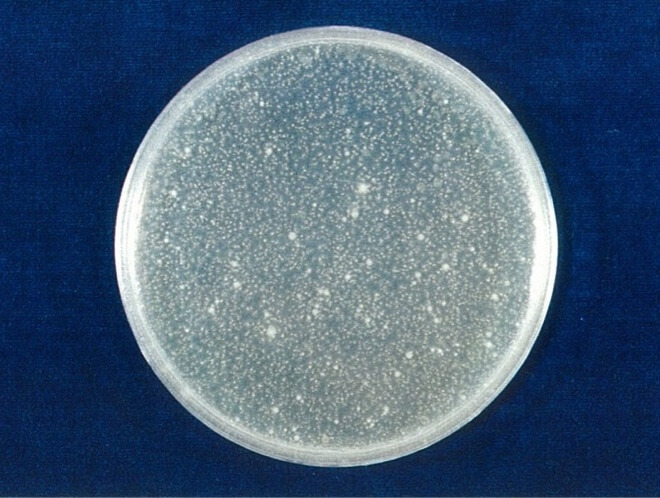
MRSA 開始時（共通写真）
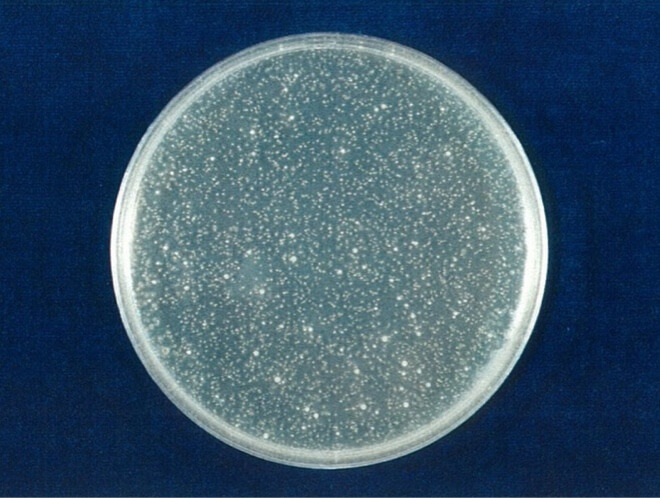
MRSA 対照 4時間後（写真-3）
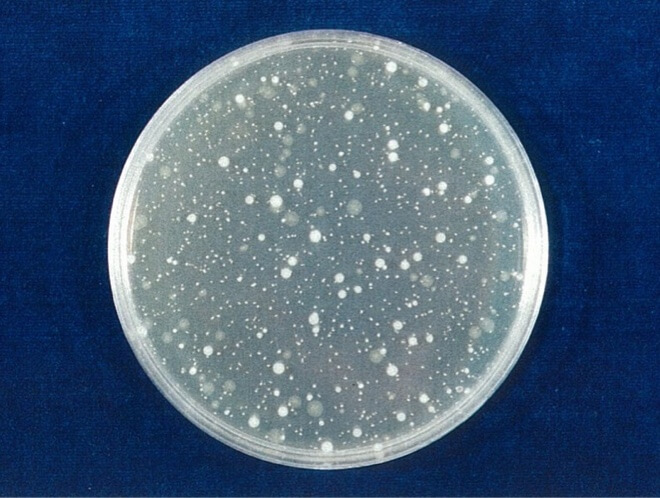
MRSA 対照 24時間後（写真-5）
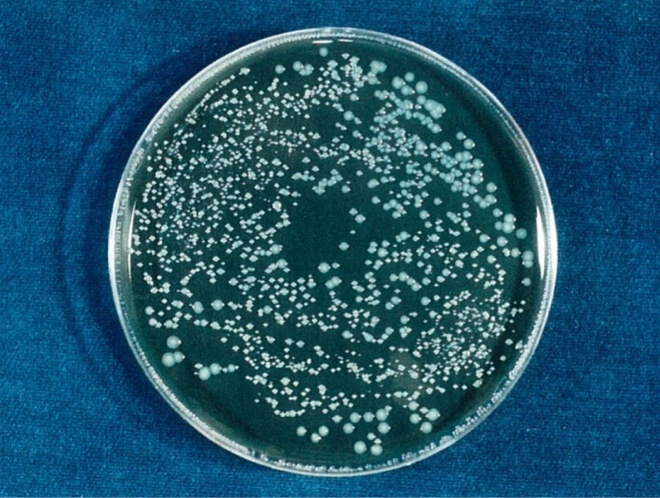
レジオネラ 開始時（共通写真）
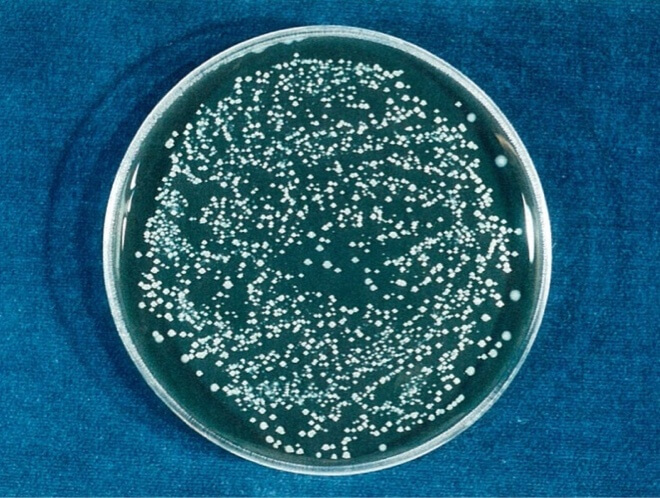
レジオネラ 対照 24時間後（写真-5）
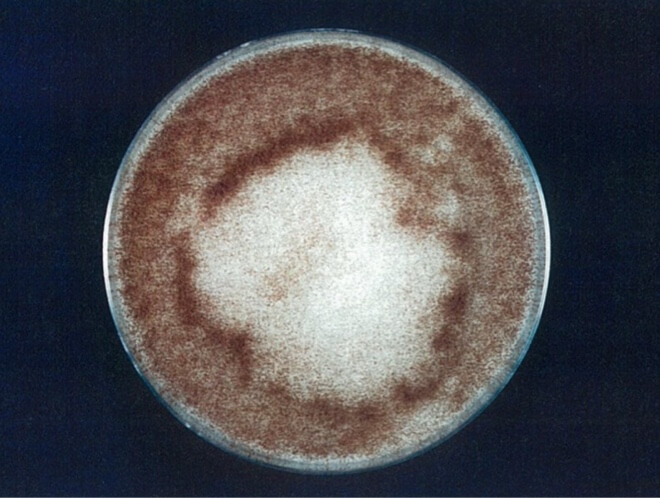
クロコウジカビ 開始時（共通写真）
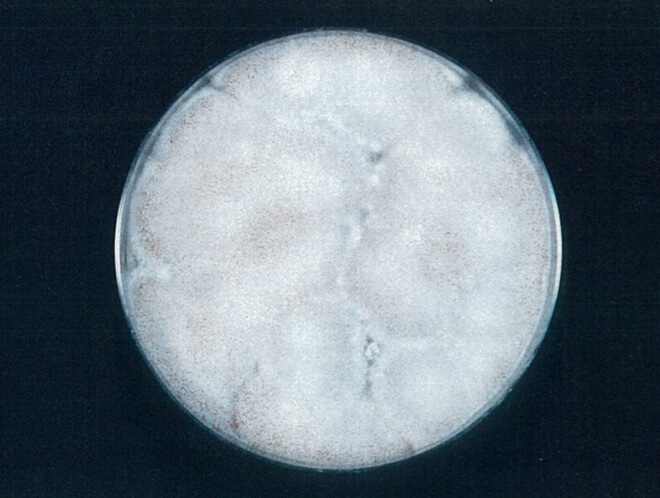
クロコウジカビ 検体 4時間後（写真-2）
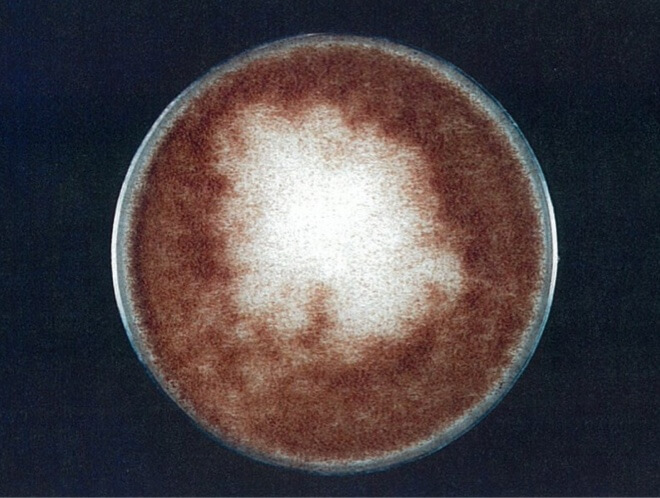
クロコウジカビ 対照 4時間後（写真-3）
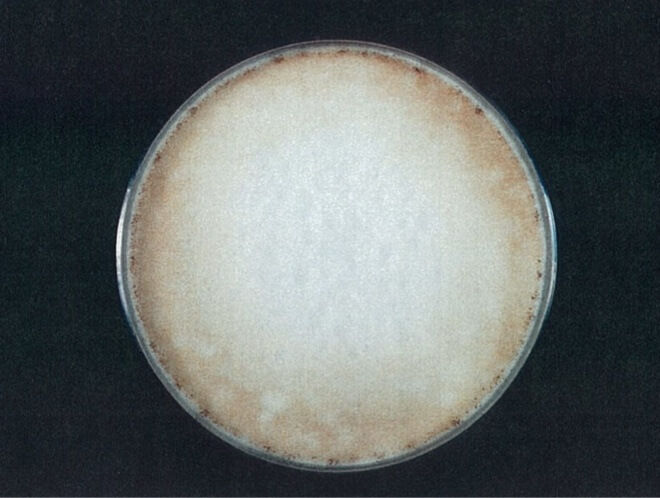
クロコウジカビ 対照 24時間後（写真-5）
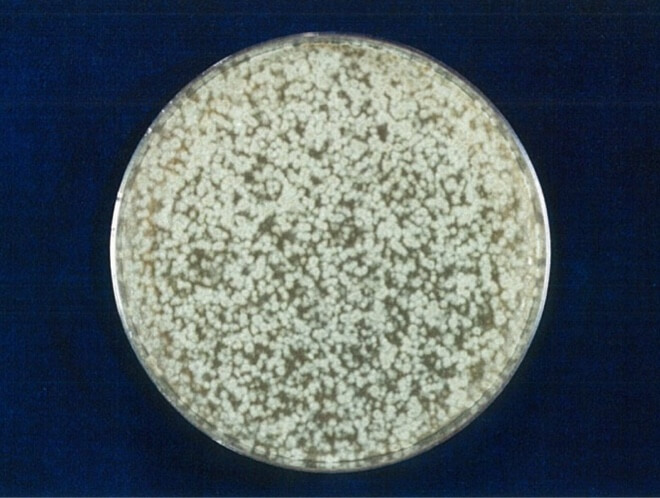
クロカワカビ 開始時（共通写真）
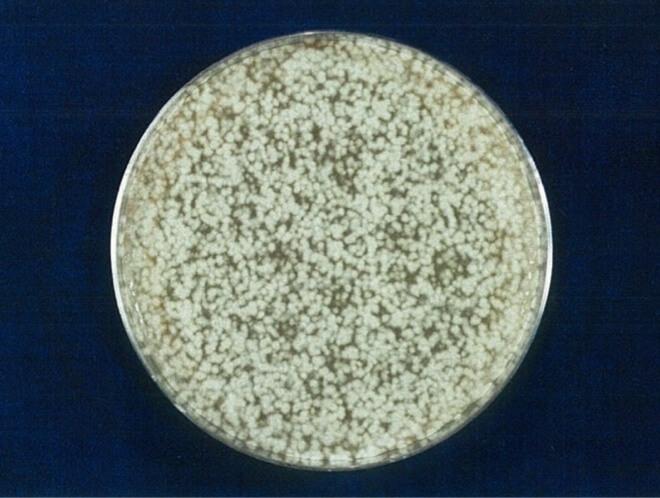
クロカワカビ 対照 4時間後（写真-3）
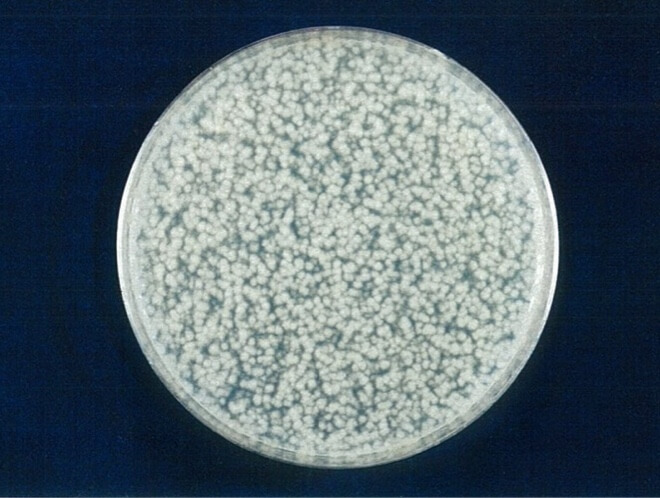
クロカワカビ 対照 24時間後（写真-5）

抗菌力試験結果

シーロマは空間の「抗菌ケア」に役立ちます
消臭抗菌アロマディフューザーSEAROMA(シーロマ)は、消臭と同時に、空間における菌やカビの増殖を抑えることを目指した製品です。
第三者機関による抗菌力試験でも、菌やカビの増殖が抑制されることが確認されました。
このページでは、シーロマの抗菌力試験の結果をご紹介します。
また、医療機関やオフィスでの実地試験(試験条件下)でも、シーロマを噴霧することで空間の菌の数が減少することが確認されました。詳細は別ページでご紹介しています。
落下菌抑制効果の検証結果
第三者試験による検証
試験の目的
生活空間で問題になりがちな細菌・カビに対し、シーロマがどの程度有効なのかを数値で可視化するため、抗菌力試験を実施。
「どの菌種に、どれくらい効くのか」「時間経過で効果はどう推移するのか」を、開始時・4時間後・24時間後の生菌数で評価した。
試験機関
財団法人 日本食品分析センター
- 試験報告書番号:第105083711-002号
- 依頼者:株式会社ピクセン
- 検体名:シーロマBK(SEAROMA BK)
使用菌種と測定方法
使用菌種(細菌・カビ)
| 区分 | 菌種 | 株番号・補足 |
|---|---|---|
| 細菌 | 大腸菌 | NBRC 3972 |
| 大腸菌(O157:H7) | ATCC 43895(ベロ毒素I/II産生株) | |
| 緑膿菌 | NBRC 13275 | |
| 黄色ブドウ球菌 | NBRC 12732 | |
| MRSA(メチシリン耐性黄色ブドウ球菌) | IID 1677 | |
| レジオネラ | Legionella pneumophila GIFU 9134 | |
| カビ | クロコウジカビ(Aspergillus niger) | IFO 6341 |
| クロカワカビ(Cladosporium cladosporioides) | IFO 6348 | |
| アオカビ(Penicillium citrinum) | IFO 6352 |
試験方法
検体(SEAROMA BK)を試験液とし、20mLに各菌液0.2mLを添加、混合後、25℃±1℃で保存し、4時間および24時間保存後に生菌数を測定した。
あらかじめ予備試験を行い、試験液を細菌はSCDLP培地、カビはGPLP培地を用いて10倍に希釈することで検体の影響を受けず生菌数が測定できることを確認した。
試験液を10倍に希釈後、レジオネラ以外の細菌はSCDLPA培地を用いた混釈平板培養法(35℃±1℃、2日間培養)、レジオネラはBCYE寒天培地を用いた平板塗抹培養法(35℃±1℃、5~6日間培養)、カビはGPLPA培地を用いた混釈平板培養法(25℃±1℃、7日間培養)により生菌数を測定し、試験液1mL当たりに換算した。
なお、生理食塩水を対照の試験液とし、同様に試験した。
試験で判明したシーロマの抗菌効果
生菌数の推移
試験の結果、検体を使用した場合、ほとんどの菌とカビは4時間で検出されないレベルまで減少し、その状態を24時間後まで維持できることが確認されました。
一方、比較に用いた生理食塩水では菌の数は大きく変化せず、わずかに減るものや逆に少し増えるものも見られましたが、全体として効果は安定せず、検体との差がより明確に示されました。
細菌:開始時/4時間後/24時間後(生菌数 /mL)
| 菌種 | 検体(SEAROMA BK) | 対照(生理食塩水) | ||||
|---|---|---|---|---|---|---|
| 開始時 | 4時間 | 24時間 | 開始時 | 4時間 | 24時間 | |
| 大腸菌 | 1.7×105 | <10(不検出) | <10(不検出) | 1.7×105 | 1.7×105 | 1.4×105 |
| 大腸菌(O157:H7) | 1.1×105 | <10(不検出) | <10(不検出) | 1.1×105 | 1.1×105 | 7.3×104 |
| 緑膿菌 | 2.1×105 | <10(不検出) | <10(不検出) | 2.1×105 | 3.1×105 | 8.5×104 |
| 黄色ブドウ球菌 | 1.1×105 | <10(不検出) | <10(不検出) | 1.1×105 | 1.0×105 | 1.1×105 |
| MRSA | 9.2×104 | <10(不検出) | <10(不検出) | 9.2×104 | 6.0×104 | 1.6×104 |
| レジオネラ | 1.2×106 | <100(不検出) | <100(不検出) | 1.2×106 | 9.9×105 | 1.3×106 |
カビ:開始時/4時間後/24時間後(生菌数 /mL)
| 菌種 | 検体(SEAROMA BK) | 対照(生理食塩水) | ||||
|---|---|---|---|---|---|---|
| 開始時 | 4時間 | 24時間 | 開始時 | 4時間 | 24時間 | |
| クロコウジカビ | 6.5×105 | 3.1×102 | 30 | 6.5×105 | 6.5×105 | 3.0×105 |
| クロカワカビ | 2.1×105 | <10(不検出) | <10(不検出) | 2.1×105 | 2.2×105 | 1.0×105 |
| アオカビ | 3.3×105 | <10(不検出) | <10(不検出) | 3.3×105 | 2.2×105 | 2.7×105 |
※検出限界未満の値は「不検出」と表示。生菌数は10倍希釈液1 mL当たり(レジオネラのみ0.1 mL当たり)。※開始時は「菌液添加直後の対照」の生菌数。
大腸菌
検体では、4時間後、24時間後ともに不検出となり、抑制が確認されたのに対し、対象ではほぼ横ばいとなり、大きな変化はなかった。
下表(および原表)を参照。

※検出限界未満の値は「不検出」と表示。
| 時間 | 開始時 | 4時間 | 24時間 |
|---|---|---|---|
| 検体 | 1.7×105 | <10(不検出) | <10(不検出) |
| 対照 | 1.7×105 | 1.7×105 | 1.4×105 |
大腸菌(O157:H7)
検体では4時間後・24時間後ともに不検出となり、抑制が確認されたのに対し、対照ではやや減少したものの全体として横ばいとなった。

※検出限界未満の値は「不検出」と表示。
| 時間 | 開始時 | 4時間 | 24時間 |
|---|---|---|---|
| 検体 | 1.1×105 | <10(不検出) | <10(不検出) |
| 対照 | 1.1×105 | 1.1×105 | 7.3×104 |
緑膿菌
検体では4時間後・24時間後ともに不検出となり、抑制が確認されたのに対し、対照では一時的に増殖後に減少となったものの、大きな変化はなかった。

※検出限界未満の値は「不検出」と表示。
| 時間 | 開始時 | 4時間 | 24時間 |
|---|---|---|---|
| 検体 | 2.1×105 | <10(不検出) | <10(不検出) |
| 対照 | 2.1×105 | 3.1×105 | 8.5×104 |
黄色ブドウ球菌
検体では、4時間後、24時間後ともに不検出となり、抑制が確認されたのに対し、対象ではほぼ横ばいとなり、大きな変化はなかった。

※検出限界未満の値は「不検出」と表示。
| 時間 | 開始時 | 4時間 | 24時間 |
|---|---|---|---|
| 検体 | 1.1×105 | <10(不検出) | <10(不検出) |
| 対照 | 1.1×105 | 1.0×105 | 1.1×105 |
MRSA(メチシリン耐性黄色ブドウ球菌)
検体では、4時間後、24時間後ともに不検出となり、抑制が確認されたのに対し、対象ではやや減少となったが全体として変化はなかった。
MRSAは抗菌薬に耐性をもち、制御が難しい菌である。

※検出限界未満の値は「不検出」と表示。
| 時間 | 開始時 | 4時間 | 24時間 |
|---|---|---|---|
| 検体 | 9.2×104 | <10(不検出) | <10(不検出) |
| 対照 | 9.2×104 | 6.0×104 | 1.6×104 |
レジオネラ
検体では、4時間後、24時間後ともに不検出となり、抑制が確認されたのに対し、対照では一度減少となった後、元の水準に戻り横ばいとなった。

※検出限界未満の値は「不検出」と表示。
| 時間 | 開始時 | 4時間 | 24時間 |
|---|---|---|---|
| 検体 | 1.2×106 | <100(不検出) | <100(不検出) |
| 対照 | 1.2×106 | 9.9×105 | 1.3×106 |
クロコウジカビ(Aspergillus niger)
検体では4時間後にわずかに検出され、24時間後にはさらに減少して抑制が確認されたのに対し、対象ではやや減少したものの横ばいであった。

※検出限界未満の値は「不検出」と表示。
| 時間 | 開始時 | 4時間 | 24時間 |
|---|---|---|---|
| 検体 | 6.5×105 | 3.1×102 | 30 |
| 対照 | 6.5×105 | 6.5×105 | 3.0×105 |
クロカワカビ(Cladosporium cladosporioides)
検体では4時間後・24時間後ともに不検出となり、抑制が確認されたのに対し、対照ではわずかに増減があったが、全体としては横ばいであった。

※検出限界未満の値は「不検出」と表示。
| 時間 | 開始時 | 4時間 | 24時間 |
|---|---|---|---|
| 検体 | 2.1×105 | <10(不検出) | <10(不検出) |
| 対照 | 2.1×105 | 2.2×105 | 1.0×105 |
アオカビ(Penicillium citrinum)
検体では4時間後・24時間後ともに不検出となり、抑制が確認されたのに対し、対照では一度減少した後に再び増加したが、全体として大きな変化はなかった。





※検出限界未満の値は「不検出」と表示。
| 時間 | 開始時 | 4時間 | 24時間 |
|---|---|---|---|
| 検体 | 3.3×105 | <10(不検出) | <10(不検出) |
| 対照 | 3.3×105 | 2.2×105 | 2.7×105 |
どの菌にどれくらい効果があったか
本検証の結果、大腸菌、大腸菌(O157:H7)、緑膿菌、黄色ブドウ球菌、MRSA、クロカワカビ、アオカビは4時間後・24時間後ともに不検出となり、強い抑制効果が確認された。クロコウジカビのみ4時間後にわずかに残存が見られたが、24時間後には大きく減少し抑制が確認された。レジオネラについては、他の菌とは測定条件が異なり0.1mLあたりの値で評価されているが、検出限界未満(<100)となり、十分な抑制が認められた。
他の除菌・抗菌製品と何が違う?
試験により、抗菌効果が持続することを確認!
今回の検証では、4時間後・24時間後に菌やカビの数を測定し、時間が経っても抑制効果が続いていることが明らかになりました。
一般的な抗菌スプレーはすぐに効果を発揮する一方で、時間が経つと効力が弱まってしまいます。
シーロマはスイッチを入れておくだけで抗菌成分を絶え間なく空間に広げるため、持続的に働き続けます。
こんな方も安心してお使いいただけます
シーロマは、スイッチを入れるだけで「消臭・抗菌・芳香」が叶う、シンプルな設計が特徴です。
24時間運転でのご使用はもちろん、例えば来客前にスイッチオンで、ニオイの不安を解消できます。

お子さまやペットがいるご家庭
食事スペースやリビング、寝室など、清潔感を保ちたい場所の空間ケアに。
スプレーの刺激感が気になる方にも、シーロマなら穏やかに効果を持続できます。
※ご使用時は取扱説明書・注意事項に従い、顔の近くやペットケージ内への直接噴霧は避け、適切な換気を併用してください。

抗菌が有効な施設(医療・介護・サロン・ホテル・飲食店など)
待合室、カウンター周り、バックヤードなど人の出入りが多い場所の印象や衛生感の底上げに。
現場試験ではドア付近や人の動きが多い位置でも菌数の減少が確認されています(試験条件下)。
